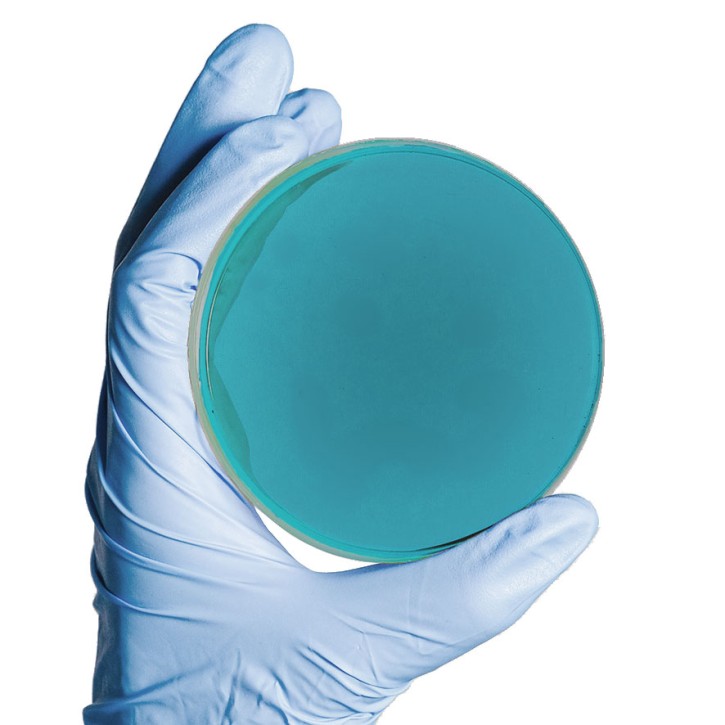

Produktbeschreibung
Die Kova Liqua-Trol Kontrollurine Level I (Positiv-Kontrolle) und Level II (Negativ-Kontrolle mit hCG) dienen als interne Qualitätskontrollen für Harnteststreifen (biochemische UND chemische Systeme, in Übereinstimmung mit den RiliBÄK B1 / B3).
Kompatibel mit vielen Harnteststreifen (bitte Validierungsinfo in der GBA der jeweiligen Harnteststreifen beachten!)
Reader sind ggf. individuell zu testen und zu validieren.
Erhältlich als 2x15ml Fläschchen mit Tropfspender oder für Vollautomaten als Gebindesatz mit 2x 120 ml.
Lieferumfang hier: 1x 15ml Level I, 1x 15 ml Level 2 in der praktischen Tropfflasche.
Downloads
Übersicht validierte Testsysteme (0.28 MB)
Übersicht validierte Testsysteme
Folgende Produkte könnten Sie auch interessieren
Impfösen 10µl - (50x 20 Stk., sterilisiert) blau, aus PE
Impfschlingen oder Impfösen gehören zur Standardausstattung jedes...
EUR 34,00 - EUR 39,00
zzgl. 19 % USt ggf. zzgl. Versandkosten
Hoyer-6 - Urinteststreifen (50 Stck)
Zur Diagnose von Erkrankungen der Nieren und ableitenden Harnwege sowie zur...
EUR 16,20
zzgl. 19 % USt ggf. zzgl. Versandkosten
U11Plus Harnteststreifen (150 Stck) für DocUReader 2 PRO und LabUReader Plus 2
LabStrip U11 Plus ist ein hochwertiger, nicht-blutender Urinteststreifen....
EUR 14,00 - EUR 19,50
zzgl. 19 % USt ggf. zzgl. Versandkosten
Der CLED Agar ist ein nicht-differenzierendes Basismedium für die Anzucht von...
EUR 7,50 - EUR 8,68
zzgl. 19 % USt ggf. zzgl. Versandkosten
MacConkey/Columbia-CNA biplate Agar - 20 Stk.
MacConkey II Agar ist ein selektives Differenzierungsmedium zur Isolierung und...
EUR 13,98 - EUR 14,50
zzgl. 19 % USt ggf. zzgl. Versandkosten
Die MICRONAUT-UR Platten dienen der Identifizierung (54 Taxa) und...
EUR 595,00
zzgl. 19 % USt ggf. zzgl. Versandkosten
DocUReader 2 PRO Harnteststreifen-Lesegerät
Der DocUReader 2 PRO , made in EUROPE, kann bis zu 50 Teststreifen pro Stunde...
EUR 499,00
zzgl. 19 % USt ggf. zzgl. Versandkosten
Küvetten für UriSed mini (600 Stck) URS-9961-1 für UriSed mini Automaten
UriSed-Küvetten sind Einwegbehälter aus Polycarbonat zur Analyse...
Preis auf Anfrage
zzgl. 19 % USt ggf. zzgl. Versandkosten
Mikroalbumin-& Kreatinin-Teststreifen (25 Stck.) für DocUReader 2 PRO
Der kombinierte Mikroalbumin- und Kreatinintest (LabStrip U mAlb/CREA) ist ein...
EUR 16,00 - EUR 23,00
zzgl. 19 % USt ggf. zzgl. Versandkosten
Kunden kauften auch
Mueller-Hinton-II Agar fertig - 20 Stk.
Der Müller-Hinton-Agar (MH-Agar) ist ein nicht-synthetisches, sparsames,...
EUR 8,68
zzgl. 19 % USt ggf. zzgl. Versandkosten
CLED / MacConkey-biplate Agar - 20 Stk.
Selektives Differenzierungsmedium zur Isolierung und Differenzierung von...
EUR 12,50 - EUR 13,75
zzgl. 19 % USt ggf. zzgl. Versandkosten
Mikroalbumin-& Kreatinin-Teststreifen (25 Stck.) für DocUReader 2 PRO
Der kombinierte Mikroalbumin- und Kreatinintest (LabStrip U mAlb/CREA) ist ein...
EUR 16,00 - EUR 23,00
zzgl. 19 % USt ggf. zzgl. Versandkosten
MacConkey-Agar fertig - 20 Stk.
Das MacConkey Medium ist ein selektives Medium für die bevorzugte Anzucht...
EUR 7,50 - EUR 8,68
zzgl. 19 % USt ggf. zzgl. Versandkosten
MICRONAUT Indol Reagenz (100ml)
Die Indolreagenz (Kovacz) ist abgestimmt auf das MICRONAUT System. Lagerung: bei...
EUR 12,50
zzgl. 19 % USt ggf. zzgl. Versandkosten
Kontakt
Bei Rückfragen erreichen Sie unser Kundenbüro telefonisch unter +49 201 21961-701 werktags von 8:00-12:00 und 13:00-17:00 Uhr.
Alternativ schicken Sie uns ein Fax an +49 2573 69795-9917 oder eine E-Mail an service@aurosan.de
Vielen Dank, Ihr Team von AUROSAN.
AUROSAN GmbH | Frankenstr. 231, D-45134 Essen | Tel. +49 201 21961-701 | Fax +49 2573 69795-9917
service@aurosan.de | www.aurosan.de | www.aurosan-shop.de | www.aurosan-gesundes-leben.de